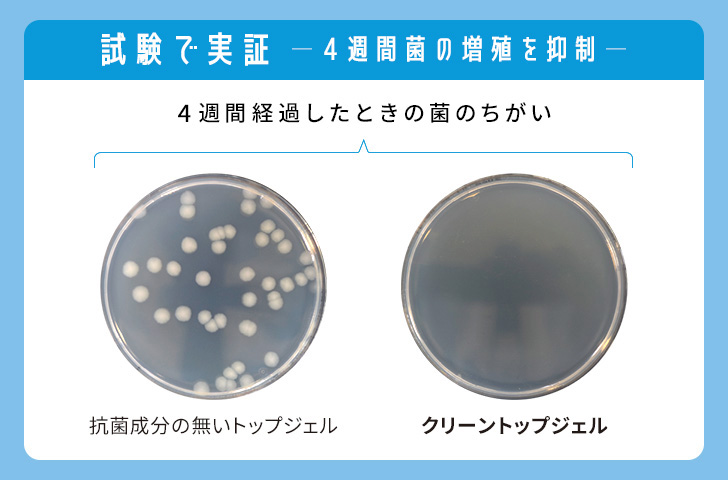

カルジェル クリーントップジェル

トップジェルに抗菌作用をプラス!
より清潔に安心を!
カルジェルの仕上げに使用するトップジェルに抗菌作用をプラス!オシャレを楽しみながら、ジェルをつけている期間菌の繁殖を防ぎ、常に清潔な爪先をキープできる新商品です。

-
※ 本試験結果は、抗菌作用「菌の増殖を抑えること」を示すものであり、「殺菌」のようにすべての菌を直接殺したり、取り除いたりする効果や「抗ウイルス作用」を示すものではございません。

-
※ 提供元:(株)衛生微生物研究センター
【試験内容】菌種:黄色ブドウ球菌、大腸菌
室温静置で4週間保管後、JIS Z 2801に基づき抗菌試験を実施
オンラインショップ
-
2025.12.12
-
2025.12.11
-
2025.12.08
-
2025.12.08
-
2025.12.04
-
2025.12.02
-
2025.12.01
-
2025.11.24
-
2025.11.18
-
2025.11.10
-
2025.11.05
-
2025.11.05
-
2025.12.12
-
2025.12.11
-
2025.12.08
-
2025.12.08
過去の新商品情報一覧